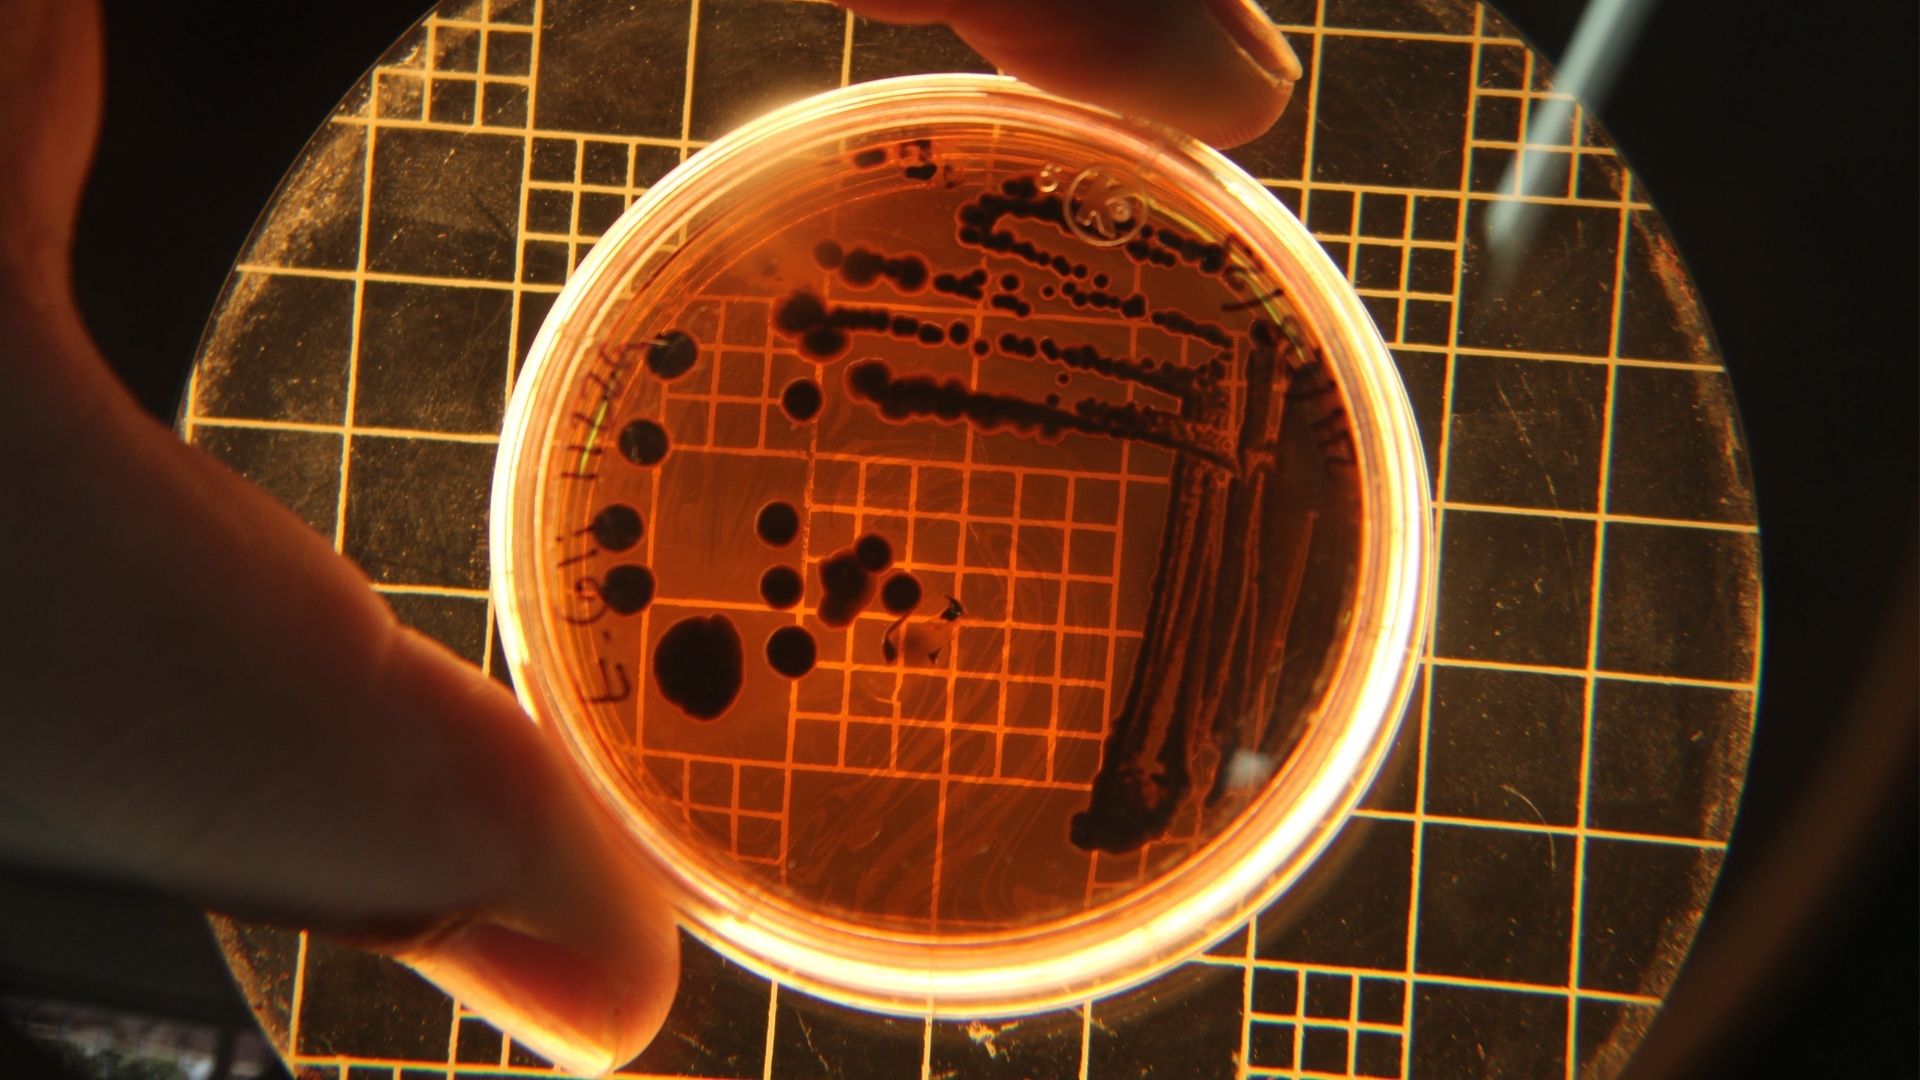
Người từng nhiễm Helicobacter pylori có thể bị tái phát bệnh

Tìm hiểu chung về bệnh viêm teo niêm mạc dạ dày
Viêm teo niêm mạc dạ dày (Chronic Atrophic Gastritis - CAG) là tình trạng viêm mạn tính kéo dài dẫn đến mất tế bào tuyến trong niêm mạc dạ dày, thay thế bằng mô xơ hoặc biểu mô dị sản ruột. Theo hệ thống phân loại Kimura-Takemoto, bệnh được chia thành các mức độ từ C1 đến O3, trong đó C2 là giai đoạn trung gian, vùng teo lan rộng từ góc bờ cong nhỏ nhưng chưa vượt quá nửa dưới thân vị.
Ở giai đoạn C2, người bệnh có thể chưa xuất hiện triệu chứng rõ ràng nhưng đã có sự suy giảm chức năng tiết dịch vị, ảnh hưởng đến quá trình tiêu hóa và hấp thu. Nếu không được kiểm soát, bệnh có thể tiến triển đến các mức độ nặng hơn, làm tăng nguy cơ loét, xuất huyết và ung thư biểu mô tuyến dạ dày.
Triệu chứng bệnh viêm teo niêm mạc dạ dày
Những dấu hiệu và triệu chứng của viêm teo niêm mạc dạ dày
Viêm teo niêm mạc dạ dày thường diễn tiến âm thầm trong thời gian dài, khiến người bệnh khó nhận biết. Tuy nhiên, khi tổn thương lan rộng và ảnh hưởng đến chức năng tiêu hóa, các triệu chứng bắt đầu xuất hiện rõ rệt hơn.
Dưới đây là những dấu hiệu và triệu chứng thường gặp:
- Người bệnh cảm thấy ăn không ngon, dễ no, đặc biệt là sau khi ăn một lượng nhỏ thức ăn.
- Có cảm giác nóng rát vùng thượng vị, đôi khi kèm theo ợ hơi hoặc ợ chua.
- Miệng có vị đắng hoặc hôi, nhất là vào buổi sáng sớm.
- Cảm giác đầy bụng, khó tiêu, đặc biệt sau các bữa ăn nhiều đạm hoặc chất béo.
- Xuất hiện tình trạng mệt mỏi, uể oải kéo dài do cơ thể không hấp thu đủ dưỡng chất.

Biến chứng có thể gặp khi mắc bệnh viêm teo niêm mạc dạ dày
Viêm teo niêm mạc dạ dày nếu không được phát hiện và điều trị kịp thời có thể dẫn đến nhiều biến chứng nguy hiểm, ảnh hưởng nghiêm trọng đến sức khỏe tổng thể và chất lượng cuộc sống. Dưới đây là những biến chứng thường gặp:
- Tình trạng dị sản ruột: Niêm mạc dạ dày bị thay thế bằng tế bào biểu mô ruột, làm tăng nguy cơ ung thư hóa.
- Loạn sản tế bào tuyến: Là giai đoạn tiền ung thư, khi các tế bào niêm mạc biến đổi bất thường về hình thái và chức năng.
- Thiếu hụt enzyme tiêu hóa: Do mất tế bào tuyến, dạ dày không còn tiết đủ pepsin và acid hydrochloric, gây rối loạn tiêu hóa kéo dài.
- Hội chứng kém hấp thu: Cơ thể không hấp thu được các vi chất thiết yếu như sắt, vitamin B12, acid folic, dẫn đến thiếu máu và suy dinh dưỡng.
- Tăng nguy cơ ung thư biểu mô tuyến dạ dày: Đặc biệt ở những người có dị sản ruột lan rộng hoặc loạn sản mức độ cao.
- Tổn thương lan rộng sang các vùng khác của dạ dày, làm mất chức năng bảo vệ và tiêu hóa.
Khi nào cần gặp bác sĩ?
Việc thăm khám chuyên khoa tiêu hóa là cần thiết để phát hiện sớm viêm teo niêm mạc dạ dày và ngăn ngừa biến chứng. Người bệnh không nên chủ quan khi xuất hiện các dấu hiệu bất thường, đặc biệt nếu thuộc nhóm nguy cơ cao.
Dưới đây là những trường hợp nên đến gặp bác sĩ:
- Có triệu chứng tiêu hóa kéo dài trên 2 tuần như đầy bụng, chán ăn, buồn nôn hoặc đau âm ỉ vùng thượng vị.
- Sút cân nhanh chóng mà không rõ nguyên nhân, dù không thay đổi chế độ ăn uống.
- Cảm thấy mệt mỏi, chóng mặt, da xanh xao là dấu hiệu của thiếu máu do kém hấp thu vi chất.
- Có tiền sử mắc viêm dạ dày, nhiễm Helicobacter pylori hoặc từng điều trị loét dạ dày.
- Có người thân từng mắc ung thư dạ dày hoặc các bệnh lý tiêu hóa ác tính.
- Đã từng nội soi phát hiện dị sản ruột, loạn sản hoặc tổn thương tiền ung thư.
- Sử dụng thuốc chống viêm không steroid kéo dài mà không có sự giám sát y tế.

Nguyên nhân gây bệnh viêm teo niêm mạc dạ dày
Viêm teo niêm mạc dạ dày là hậu quả của quá trình viêm mạn tính kéo dài. Có nhiều nguyên nhân góp phần vào sự hình thành và tiến triển của bệnh.
Dưới đây là các nguyên nhân chính:
- Nhiễm Helicobacter pylori là nguyên nhân phổ biến nhất, gây viêm mạn tính và tổn thương tế bào tuyến.
- Lạm dụng thuốc chống viêm không steroid như Ibuprofen, Diclofenac.
- Stress kéo dài ảnh hưởng đến lưu lượng máu nuôi niêm mạc.

Nguy cơ gây bệnh viêm teo niêm mạc dạ dày
Những ai có nguy cơ mắc bệnh viêm teo niêm mạc dạ dày?
Viêm teo niêm mạc dạ dày là bệnh lý mạn tính có thể ảnh hưởng đến nhiều đối tượng, nhưng một số nhóm người có nguy cơ mắc bệnh cao hơn do đặc điểm sinh lý, tiền sử bệnh lý hoặc yếu tố di truyền. Việc nhận diện đúng nhóm nguy cơ giúp bác sĩ đưa ra khuyến nghị nội soi sàng lọc phù hợp.
Dưới đây là những đối tượng dễ mắc bệnh:
- Người cao tuổi, đặc biệt từ 50 tuổi trở lên, do quá trình lão hóa làm giảm khả năng tái tạo niêm mạc.
- Người từng mắc viêm dạ dày mạn tính, đặc biệt nếu kéo dài trên 6 tháng mà không điều trị triệt để.
- Người có tiền sử nhiễm Helicobacter pylori, dù đã điều trị nhưng chưa kiểm tra lại tình trạng tái nhiễm.
- Người từng nội soi phát hiện dị sản ruột hoặc loạn sản tế bào tuyến.
Yếu tố làm tăng nguy cơ mắc bệnh viêm teo niêm mạc dạ dày
Bên cạnh các nhóm đối tượng dễ mắc bệnh, một số yếu tố môi trường và lối sống có thể thúc đẩy tiến triển của viêm teo niêm mạc dạ dày. Việc kiểm soát các yếu tố này đóng vai trò quan trọng trong phòng ngừa và điều trị bệnh.
Dưới đây là những yếu tố làm tăng nguy cơ mắc bệnh:
- Chế độ ăn uống không lành mạnh: Ăn nhiều thực phẩm chế biến sẵn, ít rau xanh, nhiều chất béo và chất bảo quản làm tăng nguy cơ tổn thương niêm mạc.
- Lạm dụng thuốc chống viêm không steroid (NSAIDs): Sử dụng kéo dài các thuốc như Ibuprofen, Diclofenac gây tổn thương niêm mạc.
- Stress kéo dài: Căng thẳng thần kinh ảnh hưởng đến hệ thần kinh ruột, làm giảm khả năng phục hồi tổn thương.
Phương pháp chẩn đoán và điều trị bệnh viêm teo niêm mạc dạ dày
Phương pháp xét nghiệm và chẩn đoán viêm teo niêm mạc dạ dày
Việc chẩn đoán và điều trị viêm teo niêm mạc dạ dày cần được thực hiện bởi bác sĩ chuyên khoa tiêu hóa. Phương pháp chẩn đoán gồm:
- Nội soi tiêu hóa trên để phát hiện vùng teo niêm mạc.
- Sinh thiết mô học để phân tích mức độ mất tế bào tuyến, dị sản ruột hoặc loạn sản.
- Xét nghiệm Helicobacter pylori để xác định tình trạng nhiễm khuẩn.
- Xét nghiệm máu để đánh giá thiếu máu và dấu hiệu ung thư hóa.
Phương pháp điều trị viêm teo niêm mạc dạ dày
Dựa vào kết quả chẩn đoán có được, bác sĩ có thể lựa chọn chỉ định các phương pháp điều trị gồm:
- Điều chỉnh chế độ ăn uống và sinh hoạt.
- Theo dõi định kỳ bằng nội soi.
- Bổ sung vi chất như sắt, vitamin B12 và acid folic.
- Điều trị bệnh lý nền đi kèm.
- Tiệt trừ Helicobacter pylori bằng phác đồ kháng sinh kết hợp thuốc ức chế bơm proton.
Chế độ sinh hoạt và phòng ngừa bệnh viêm teo niêm mạc dạ dày
Những thói quen sinh hoạt có thể giúp bạn hạn chế diễn tiến của viêm teo niêm mạc dạ dày
Chế độ sinh hoạt:
Việc duy trì chế độ sinh hoạt khoa học đóng vai trò quan trọng trong kiểm soát tiến triển của viêm teo niêm mạc dạ dày. Những thói quen hàng ngày ảnh hưởng trực tiếp đến khả năng phục hồi niêm mạc và hiệu quả điều trị.
Người bệnh nên thực hiện các nguyên tắc sau:
- Ăn uống đúng giờ, không bỏ bữa, tránh ăn quá no hoặc quá đói.
- Tập thể dục nhẹ nhàng như đi bộ, yoga hoặc đạp xe để tăng cường tuần hoàn và hỗ trợ tiêu hóa.
- Ngủ đủ giấc, hạn chế thức khuya và tránh sử dụng thiết bị điện tử trước khi ngủ.
- Giữ tinh thần thoải mái, tránh căng thẳng kéo dài vì stress ảnh hưởng đến lưu lượng máu nuôi niêm mạc.
- Không hút thuốc lá, hạn chế rượu bia và các chất kích thích gây hại cho niêm mạc dạ dày.
- Khám sức khỏe định kỳ, đặc biệt là nội soi tiêu hóa nếu thuộc nhóm nguy cơ cao.
- Tránh sử dụng thuốc chống viêm không steroid kéo dài nếu không có chỉ định của bác sĩ.

Chế độ dinh dưỡng:
Dinh dưỡng đóng vai trò thiết yếu trong việc bảo vệ và phục hồi niêm mạc dạ dày. Một chế độ ăn uống phù hợp giúp giảm kích thích niêm mạc, tăng cường miễn dịch và cải thiện khả năng hấp thu vi chất.
Người bệnh nên tuân thủ các nguyên tắc sau:
- Ưu tiên thực phẩm tươi sống, chế biến đơn giản như hấp, luộc.
- Ăn nhiều rau xanh, trái cây tươi, thực phẩm giàu chất xơ để hỗ trợ nhu động ruột và giảm viêm.
- Tránh các món ăn quá cay, quá nóng hoặc quá lạnh gây kích ứng niêm mạc.
- Bổ sung vi chất cần thiết như sắt, vitamin B12, acid folic theo chỉ định của bác sĩ.
Phương pháp phòng ngừa viêm teo niêm mạc dạ dày
Hiện chưa có phương pháp đặc hiệu phòng ngừa viêm teo niêm mạc dạ dày. Do đó, các biện pháp dự phòng chủ yếu tập trung vào kiểm soát nguyên nhân gây bệnh và duy trì lối sống lành mạnh.
Người bệnh nên áp dụng các phương pháp sau:
- Tiệt trừ Helicobacter pylori triệt để theo phác đồ kháng sinh kết hợp thuốc ức chế bơm proton.
- Nội soi định kỳ để phát hiện sớm tổn thương niêm mạc, đặc biệt với người có tiền sử viêm dạ dày mạn tính hoặc dị sản ruột.
- Tránh sử dụng thuốc chống viêm không steroid kéo dài nếu không có chỉ định rõ ràng.
- Duy trì chế độ sinh hoạt và dinh dưỡng lành mạnh như đã nêu ở trên.
- Không hút thuốc lá, hạn chế rượu bia và các chất kích thích gây hại cho niêm mạc.
- Giảm stress, ngủ đủ giấc, tăng cường vận động nhẹ nhàng mỗi ngày.
- Bổ sung vi chất cần thiết để hỗ trợ phục hồi niêm mạc và cải thiện tình trạng thiếu máu.

Viêm teo niêm mạc dạ dày là bệnh lý mạn tính cần được phát hiện và điều trị kịp thời để tránh biến chứng. Việc duy trì chế độ ăn uống lành mạnh, hạn chế stress và tuân thủ hướng dẫn của bác sĩ đóng vai trò quan trọng. Thăm khám định kỳ giúp kiểm soát tiến triển bệnh và nâng cao chất lượng cuộc sống cho người bệnh.
:format(webp)/470051785_8767135473405056_691967411107495592_n_6b2bbff755.png)
:format(webp)/467434554_545745841560409_1066418224364723785_n_560a494f9c.png)
:format(webp)/viem_teo_niem_mac_da_day_6e3e904d8e.jpg)
/viem_da_day_ta_trang_bcf8067d0b.png)
/viem_da_day_hp_7be4ee9545.png)
/viem_da_day_ruot_cap_55d534509f.png)
/viem_niem_mac_da_day_065ce8ad75.png)
/viem_xung_huyet_hang_vi_da_day_00a9aa3019.jpg)